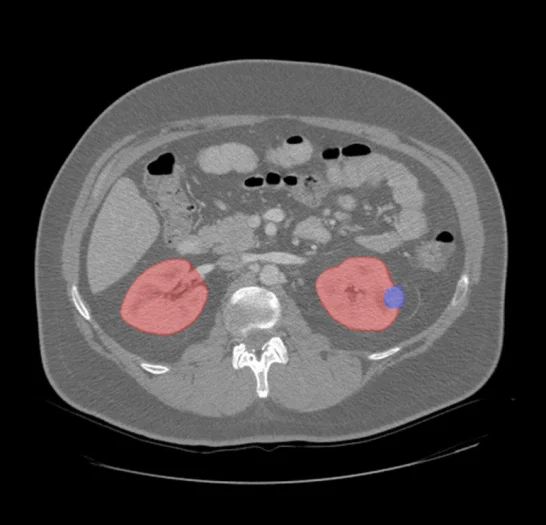

Nephrology
Pareidolia Systems provides high-precision renal imaging annotation and segmentation services that power reliable AI-driven nephrology diagnostics. Our clinical experts meticulously label and segment renal structures, vessels, lesions, and calcifications using advanced medical image annotation tools to ensure clean, consistent, and clinically valid datasets.
Each dataset undergoes multi-stage quality assurance and radiologist validation to maintain fidelity, accuracy, and medical relevance. By delivering structured, DICOM/NIFTI data, Pareidolia Systems enables AI algorithms to detect renal pathologies, quantify hydronephrosis, and assess kidney function with superior diagnostic precision. We help healthcare innovators and medical imaging companies build trustworthy, high-performing AI models for renal disease analysis and clinical decision support.